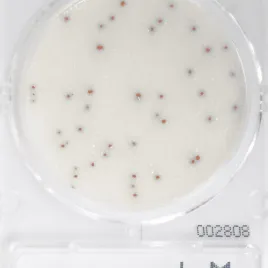

- Новинки
- Акции
- КАТАЛОГ ДИП-СЛАЙДЫ AIDIAN OY
- КАТАЛОГ ДИП-СЛАЙДЫ RTA
- Микроорганизмы
- Анализ пищевых продуктов
- ДИП-СЛАЙДЫ для определения микробиологического загрязнения
- Клиническая микробиология
- Наборы для выделения нуклеиновых кислот (ДНК/РНК)
- Наборы для выделения ДНК микобактерий из клинических образцов
- Наборы для выделения вирусной ДНК
- Наборы для выделения вирусной РНК
- Наборы для выделения вирусной нуклеозидной кислоты
- Наборы для выделения геномной ДНК из бактерии
- Наборы для выделения геномной ДНК из крови
- Наборы для выделения геномной ДНК из ткани
- Наборы для выделения полной нуклеиновой кислоты
- Наборы для выделения нуклеиновых кислот (ДНК/РНК)
- Промышленная микробиология
- Реактивы и расходные материалы для научных исследований
- Наборы для выделения нуклеиновых кислот (ДНК/РНК)
- Набор для выделения ДНК из растений и пищевых продуктов
- Набор для выделения ДНК из фиксированных формалином и залитых парафином образцов
- Наборы для выделения ДНК микобактерий из клинических образцов
- Наборы для выделения вирусной ДНК
- Наборы для выделения вирусной РНК
- Наборы для выделения вирусной нуклеозидной кислоты
- Наборы для выделения геномной ДНК из бактерии
- Наборы для выделения геномной ДНК из крови
- Наборы для выделения геномной ДНК из ткани
- Наборы для выделения полной нуклеиновой кислоты
- Наборы для выделения нуклеиновых кислот (ДНК/РНК)
- Биохимия
- Микробиологические экспресс тесты
- Микробиологические красители
- Экспресс тесты для контроля эффективности мойки и дезинфекции
- Экспресс анализ на пищевые аллергены
- Количественное определение катионов и анионов в воде
- Люминометры и АТФ тесты
- Пробоподготовка
- Дополнительное оборудование и аксессуары